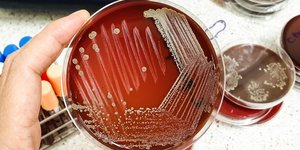

ΕΞΑΠΛΩΣΗ
OΛΕΣ ΟΙ ΕΙΔΗΣΕΙΣ ΚΑΙ ΤΑ ΤΕΛΕΥΤΑΙΑ ΝΕΑ ΓΙΑ ΤΟ TAG ΕΞΑΠΛΩΣΗ

ΚΟΣΜΟΣ 18/09/2023 13:16
Λιβύη: ΟΗΕ και ΠΟΥ ανησυχούν για τον κίνδυνο εξάπλωσης ασθενειών



ΚΟΣΜΟΣ 31/12/2022 08:55
ΗΠΑ-Κορωνοϊός: Εξαπλώνεται ταχύτατα νέα υποπαραλλαγή της Όμικρον


